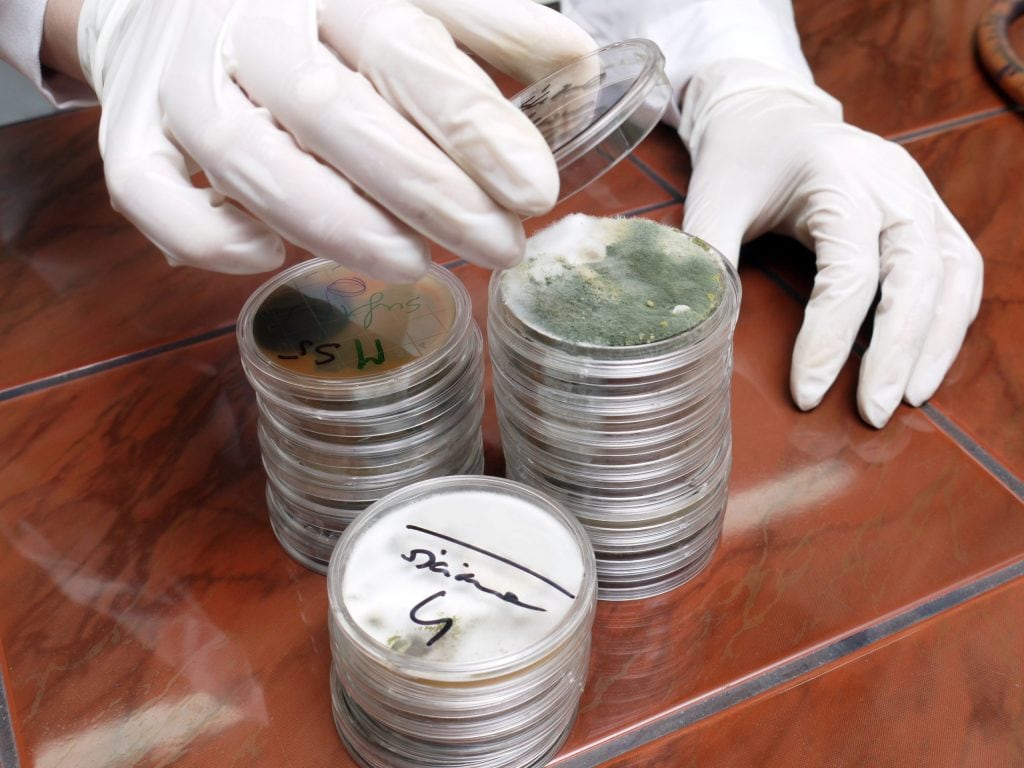
impact of mold

The Impact of Mold on Your Home and Indoor Air Quality
Mold is usually a result of water damage that hasn’t been dealt with properly. It breaks down organic materials and can be destructive to both your home and your health. The impact of mold often reaches further than people expect, affecting both the home itself and the quality of the air inside it.
The Impact of Mold on Your Home
1. Structural and Material Damage
A home that has been made damp by water damage or excess moisture is the ideal breeding ground for mold. It can form within 24 to 48 hours, spreading as it feeds on both building materials and your personal belongings.
Depending on the origin of the mold, the first things to suffer will be:
- The insulation: Given the absorbent nature of insulation, it is one of the most vulnerable materials mold can get to. Insulation is everywhere, so once mold spreads to it, you need to deal with it quickly.
- Drywall and ceilings: Typically porous, meaning mold will spread through and weaken these materials quickly. It’ll reveal itself visibly as black, green, or white patches on these surfaces.
- The structural framework of your home: Mold can weaken wood framing and other structural materials over time.
Because of how damaging mold can be, often the only solution to these issues is the complete removal and replacement of these materials.
Unfortunately, the impact of mold is not limited to building materials. With enough time, mold will eventually spread to your furniture, carpets, clothing, and personal items. Once it has laid its claim, it’s nearly impossible to restore your items to their original state.
2. HVAC Contamination
In some cases, airborne mold spores can get into your HVAC system. These spores may thrive in the system thanks to the combination of constant moisture from the cooling system and a food source – like dirt or dust. Sometimes this can result in minor mold growth, which can be cleaned by a professional. Other times, it’s highly disruptive and leads to:
- Further spreading of mold spores
- Restricted airflow due to clogging, which reduces the efficiency of the system.
- Musty and earthy odors
- Damage to HVAC components.
Health Issues Related to Mold Exposure and Poor Air Quality
There are three types of mold:
- Allergenic: Allergenic mold is not particularly dangerous and has been breathed in by everyone at one point or another. Common symptoms that may follow after accidentally breathing them in are:
- Sneezing and nasal congestionItchy or watery eyesCoughing or throat irritation
- Wheezing or shortness of breath
You only need to worry if you’re experiencing these symptoms more than usual.
- Pathogenic: This type of mold can cause an infection – especially in those who are immunocompromised.
- Toxigenic: It may create a metabolic byproduct called mycotoxins – which can be toxic to humans and animals.
What to Do If You Notice Signs of Mold Damage
- Find the moisture source. Check for leaks, condensation, poor ventilation, or past water damage that may be feeding the mold growth.
- Do not ignore visible signs. Staining, musty odors, and damaged materials often mean the problem is spreading further than what you can see.
- Avoid disturbing the area too much. Scrubbing or tearing into mold-damaged materials can release more spores into the air.
- Protect nearby areas if needed. Limit airflow and movement around the affected space so mold does not spread further through the home.
- Watch for indoor air quality changes. If you notice worsening allergy symptoms, odors, or dust-like buildup around vents, the issue may be larger than it appears.
- Call a professional team when the damage is widespread or hidden. If mold may be inside walls, insulation, ceilings, crawlspaces, or HVAC components, professional evaluation is the safest next step.
If you’re concerned that you may have mold damage, the Dryco team is ready to help. Give us a call, and we’ll send someone over to evaluate the situation and advise you on how to deal with it.